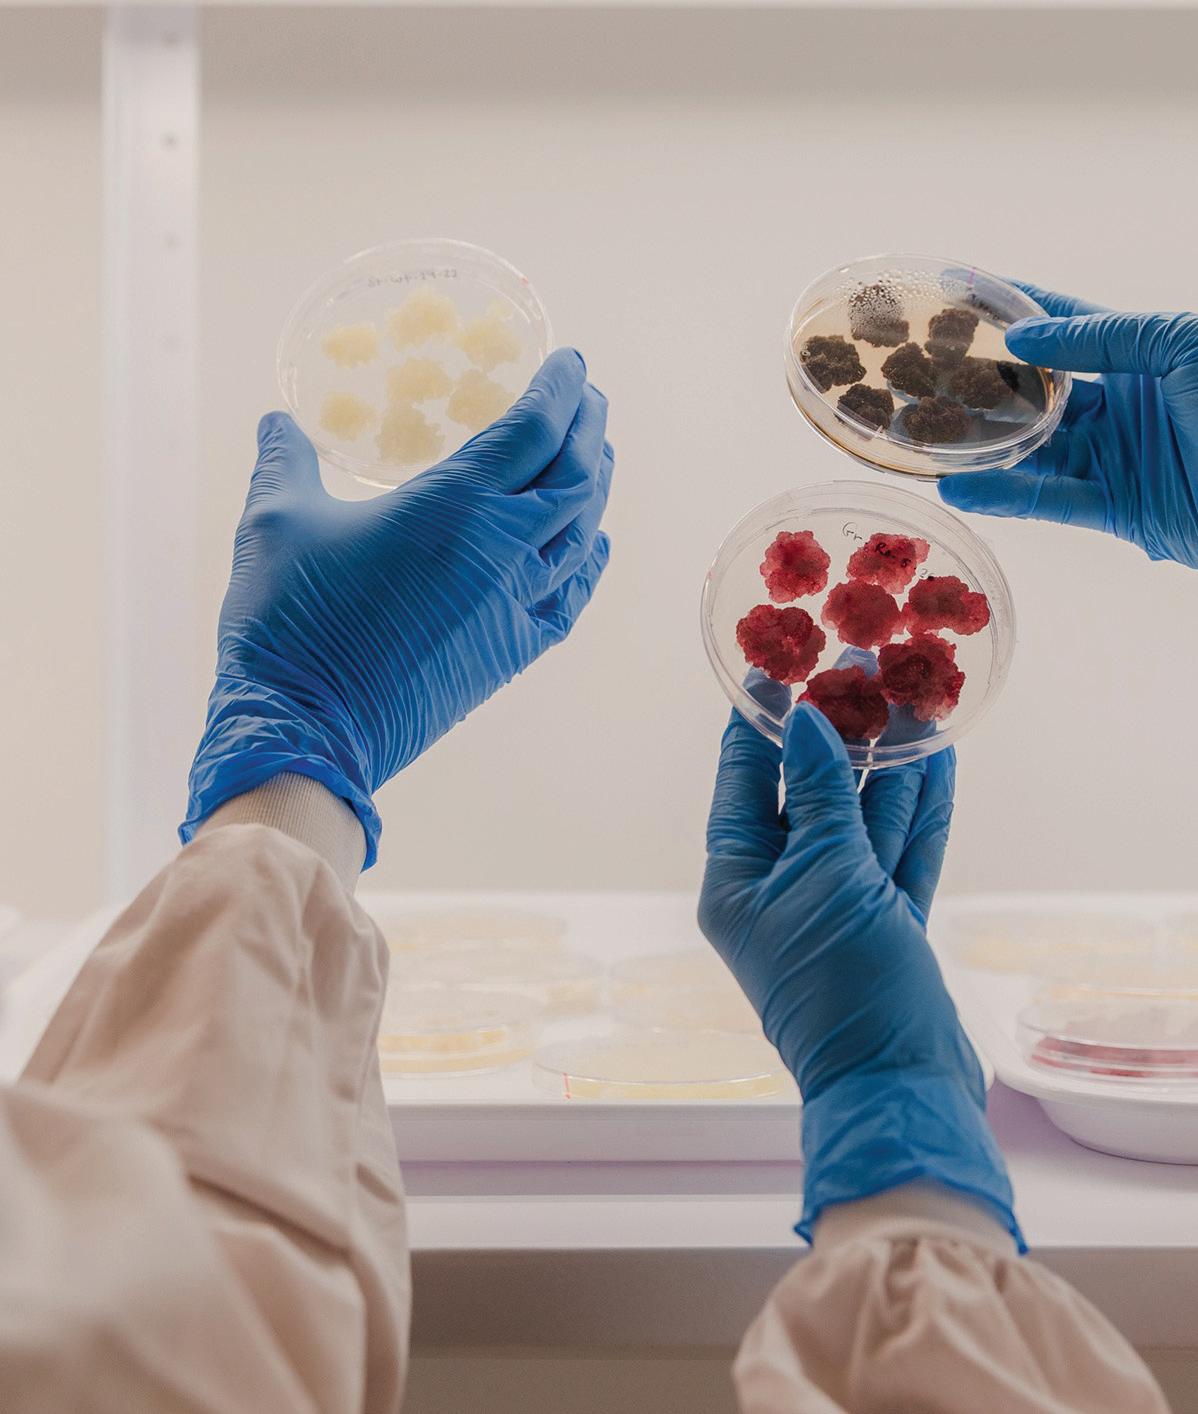

![]()



F+B
TECH Magazine Publisher
For food and beverage manufacturers, growth rarely comes from standing still. New customers, new channels, new ideas and new ways of thinking tend to emerge when you step outside your own four walls and into conversations with others who understand the pressures of making, scaling and selling product. That is where networking stops being a buzzword and starts becoming a commercial advantage.
This Buyers Guide exists to help manufacturers navigate suppliers, services and partners that can support that journey. But it also sits alongside something equally important: connection. Belonging to industry groups, showing up at the right events, and staying curious about what is happening beyond your immediate market all shape how competitive and resilient your business becomes.
Why connection matters more than ever. Manufacturing can be isolating. Long lead times, compliance demands, supply chain pressures and margin scrutiny often mean founders and operators spend most of their time solving problems internally. The risk is that you end up recycling the same ideas and missing what is shifting around you.
Groups such as Inspire+ exist precisely to break that pattern. They create a sense of belonging in an industry that is often fragmented. Conversations with peers who are dealing with the same raw
material challenges, buyer negotiations or production bottlenecks can be as valuable as any formal consultancy. You hear what is working, what is not, and where opportunities are opening up before they become obvious.
Networking at this level is not about selling. It is about listening, learning and being visible. Over time, those relationships become referral pathways, collaboration opportunities and sometimes the difference between pushing through a tough period or stalling. Looking beyond our borders. Global exhibitions play a similar role, but on a much larger stage. Events such as ANUGA, GULFOOD, ISM, SIAL and FHA are not just about big stands and new product launches. They are about immersion.
Walking these halls gives manufacturers a real sense of where global innovation is heading. Ingredients, formats, flavours, packaging, sustainability claims and processing technologies all show up here first. Just as importantly, these shows are meeting grounds. You find yourself talking to suppliers, distributors, buyers and fellow manufacturers from markets you may never otherwise encounter. Those conversations can reshape how you think about your own product and where it could travel.
A strong Buyers Guide is about more than listings. It is about helping manufacturers plug into an ecosystem. When you combine trusted suppliers, active industry networks and exposure to global ideas, you give your business more than tools. You give it perspective. And in a sector moving as quickly as food and beverage, perspective is often the most valuable asset of all.
Publisher
Tania Walters
General Manager
Kieran Mitchell
Editorial Director
Caitlan Mitchell
Content Managers
Caroline Boe
Daniel Rogers
Editorial Associates
Jenelle Sequeira
Sam Francks
Graphic Designer
Raymund Santos
Contact Us
Retail 6, Heards Building, 2 Ruskin Street, Parnell, Auckland, New Zealand
+64 9 304 0142 info@reviewmags.com
ISSN 2744-3566 (ONLINE) ISSN 2744-5895 (PRINT)
F&B
launched to facilitate the connection between food and beverage suppliers of technology, ingredients and packaging across the food and beverage manufacturing sectors for fmcg and foodservice. Copyright 2026
Our Partners:















Discover the industry-acclaimed range of product control and inspection solutions
Modular design and seamless integration



Your trusted local partner in New Zealand

The food and beverage industry is complex by nature. Behind every flavour, ingredient, or finished product sits a web of specifications, supplier documents, compliance checks, formulations, and approvals. While innovation often takes centre stage, much of the real work happens quietly in the background, managing processes that are essential but time-consuming.
At Pacific Flavours & Ingredients, we saw an opportunity to rethink how this work gets done. Not by cutting corners, and not by replacing people, but by using Generative AI to support teams and remove unnecessary friction from everyday processes.
There is a lot of noise around AI, and much of it can feel overwhelming or disconnected from day-to-day operations. In a regulated manufacturing environment, accuracy, traceability, and accountability matter too much to hand decisions over to technology alone.
Our approach has been simple. Generative AI should act like an extra team member working quietly in the background. One that helps organise information, highlights gaps, and speeds up routine tasks, while final decisions always remain with people.
Instead of asking “what can AI replace?”, we asked a more practical question: “What slows our teams down every day, and how can AI help with that?”
When AI is used to support people, it can unlock meaningful efficiency. It frees teams from repetitive tasks, reduces manual errors, and allows expertise to be applied where it matters most.
Some of the biggest efficiency gains have come from areas that are often overlooked but critical to operations.
Documentation is a clear example. Supplier specifications, certificates of analysis, allergen statements, and compliance documents frequently arrive in different formats and with varying levels of detail. Reviewing, checking, and organising these manually takes time and focus.
With Generative AI built into our workflows, much of this information can be structured, reviewed, and flagged more quickly. Teams can see what is missing, what needs attention, and what is already approved without having to search through folders, emails, or spreadsheets.
Regulatory checks are another area where AI adds real value. Whether it is assessing ingredients against local requirements or preparing information for customers and audits, AI helps bring the right information together faster. This reduces back-and-forth and allows teams to respond with greater confidence.
Formulation and product changes have also become easier to manage. When ingredients are updated or substituted, AI-assisted systems help track those changes and their downstream impact, ensuring quality and compliance considerations are not missed.
“Generative AI works best in food manufacturing when it supports people, not when it tries to replace them.”

Efficiency only matters if it comes with control.
Every AI-supported output at Pacific Flavours & Ingredients is reviewed by people. The technology helps surface information and insights, but accountability remains human. This is especially important in food manufacturing, where safety, quality, and trust are non-negotiable.
By treating AI as a support layer rather than a decision-maker, we have been able to improve speed without sacrificing rigour.
To support this approach, Pacific Flavours & Ingredients works closely with Olif, an AI-powered platform built specifically for food and beverage businesses.
What sets Olif apart is its focus on real operational challenges. Rather than offering generic AI tools, the platform is designed around how manufacturers actually work. Compliance checks, ingredient validation, documentation workflows, and cross-team collaboration are built into the system from the ground up.
By using Olif, AI has been integrated directly into daily processes, rather than sitting as a separate tool that teams have to adapt to. This makes adoption easier and ensures the technology supports existing ways of working.
The result is not just faster processes, but clearer visibility and more consistent outcomes across the business.
The pressures facing food and beverage manufacturers are only increasing. Supply chains are becoming more complex, regulations continue to evolve, and customers expect faster turnaround without compromising safety or quality.
Generative AI offers a way to meet these demands, but only when applied thoughtfully.
Our experience shows that when AI is used to support people, it can unlock meaningful efficiency. It frees teams from repetitive tasks, reduces manual errors, and allows expertise to be applied where it matters most.
At Pacific Flavours & Ingredients, leveraging Generative AI with Olif is less about adopting new technology and more about changing how work gets done. Olif, a New Zealand–built Generative AI platform, acts as an intelligent operating layer across compliance, documentation, and product workflows, bringing order to complex processes and giving teams the confidence to move faster without losing control.
As the industry looks ahead, manufacturers that combine strong technical foundations with practical AI tools will be better positioned to adapt, scale, and succeed.


Renewable energies are ready to power the food and beverage sector as gas supplies continue to decline, says University of Canterbury Associate Professor David Dempsey.

University of Canterbury Associate Professor
For decades, fossil gas has fuelled the country’s food and beverage industry. But warnings about future gas shortages should have everyone thinking about their long-term energy strategy.
Gas supplies out of Taranaki won’t disappear overnight. But the flow from currently operating gas fields is declining faster than it can be replaced, which means shortages and price rises could become more common.
Companies have already identified some offshore gas fields from previous exploration. Some of these might be developed and delivering gas in a few years, although previously, the economics have not stacked up.
Brand-new gas discoveries – the kind our Government is trying to entice overseas companies to invest in – are much more uncertain: probably 6 to 10 years to find, develop and bring to market. Others think it could be sooner, but no one really knows.
New Zealand’s political parties have differing positions on the exploration for more offshore gas. The future uncertainty this creates in the energy sector has chilled the appetite for overseas investors to spend large amounts of money here.
All up, gas users should expect that with every coming year, there will be a little less gas to go around. If something like a
dry year hits New Zealand’s hydro lakes, that could turn into a lot less gas. That’s a recipe for high fuel prices on the spot market, and higher negotiated contracts.
For some things we make – ammoniabased fertiliser, methanol – gas is the only option. But those using gas to produce heat have an opportunity to switch to reliable, renewable fuels. Switching sooner rather than later frees up supply for other industries that cannot.
In good news, Kiwi companies are in a unique position to choose a wellestablished renewable source that best suits their needs: electricity, geothermal or bioenergy. The latter two options are mostly unavailable or unaffordable in other parts of the world.
Hydro dams, geothermal plants, wind and solar farms produce 85 per cent of the country’s power in an average year, making our electricity some of the lowest emitting in the world.
While large electricity users can often access fixed costs through power purchasing agreements, smaller companies have experienced steadily rising electricity tariffs, which we should expect to keep fluctuating in coming years.
For temperatures around 150-200C or lower, electric heat pumps are a good option – performing even better if they take advantage of waste heat.
Geothermal heat has the advantage of no ongoing fuel costs, once the plant is installed. Geothermal steam also carries up gas from the Earth, potentially replacing the need for supplementary CO2 in greenhouses – though this does add to this fuel’s carbon footprint.
Of course, this option is restricted to the geothermal regions of the country, but well-located companies in Northland and the central North Island might consider it.
Above the 200C mark, factories will need to look at electric heating, hydrogen or bioenergy.
New Zealand’s massive forestry sector produces millions of tonnes of residue or waste, often known as “slash”, each year.
In the past, this waste was left to rot, post-harvest. As storms become fiercer, large boughs and stumps can wash off hills and into rivers, where the material becomes debris capable of damaging homes and bridges. Increasingly, this waste is being collected and transformed into wood chips, hog fuel or pellets that power renewable boilers across the country.
Made from a waste material, bioenergy (or wood energy) from slash is a near netzero carbon fuel, beyond the fossil fuels used in production and transportation. Because the wood absorbed CO2 from the air as it grew, large bioenergy plants also have the potential to produce highgrade “green” CO2 – gas that doesn’t add to the problem of climate change.
This opportunity is currently being explored in research led out of the University of Canterbury. You would need additional technology, beyond a standard wood-burning boiler, to capture and purify this gas from pollutants. However, producing high-grade “green” CO2 could offer an alternative revenue stream to a major bioenergy user.
Whatever the alternative fuel, replacing your fossil gas plant before it reaches the end of its life carries a cost. But switching to renewable energy addresses the longerterm risk of reliance on our uncertain gas sector.
Kiwi engineers have been transitioning companies from fossil to renewable energy for more than a decade. They know how to do it.
⮞ For more, the Energy Efficiency and Conservation Authority (eeca.govt.nz) offers a wealth of information, as does the Bioenergy Association (bioenergy.org.nz).

Dieuwertje Raaijmakers, Marketing Communications Specialist at EXBERRY® by GNT, explains how colour can help manufacturers tap into a growing trend for shared food and drink experiences.
At a time of instability and isolation, people all over the world are increasingly coming together through consumption. They’re using food and drink as a force for connection, cultural exploration, care and creativity – sparking moments of joy and escapism through shared experiences.
Gather Together, the new research project from EXBERRY® by GNT, shows how colour can help manufacturers create products that resonate in this new era.
Developed alongside research agency FranklinTill, Gather Together lifts the lid on emerging consumer behaviours and provides practical advice on using colour to help create the experiences that consumers crave.
This feature focuses on two of the four new trend directions we have identified in line with this movement. It also explores their associated colour palettes and provides concept inspiration to show how our plant-based EXBERRY® colours can bring them to life.
People are gathering within their community to cook and eat together, using food as a form of care and connection to unite consumers of different ages, economic backgrounds and beliefs.
Understanding the trend: People are gathering within their community to cook and eat together, using food as a form of care and connection to unite consumers of different ages, economic backgrounds and beliefs. Joyful Unity can be seen in the rise of community bakeries and canteens as well as social events such as cake picnics and food-powered creative workshops.
Key colors: The colors of Joyful Unity evoke simple, seasonal, soul-soothing meals and drinks. They include the warm, rich reds and pinks seen in sun-dried tomatoes, beetroot and peppers, the bright greens of spinach and okra, and the comforting browns and beiges of baked goods such as golden challah and salted pretzels.
Concept inspiration: Tap into the trend with products ranging from sourdough breads coloured with nutritious rootvegetable colours and tomatoes through to yoghurt drinks with vegetable flavours and rich greens, reds and pinks.
Understanding the trend: People are finding joy and comfort in regional dishes and ingredients tied to their roots, helping them come together to share flavours and family recipes. The Cultural Celebration trend is most strongly associated with Southeast Asian cuisine but it’s also emerging among African and Latin American diaspora and beyond.
Key colors: This palette is inspired by traditional regional foods and hyper-

niche flavours. It includes bold, energetic, saturated colours drawn from ingredients such as spiced marigold, hibiscus-glazed red, burnt persimmon and plum. It also features sun-ripened and intense yellow and orange tones as well as the deep, warm yellow-toned and herbal greens of curry leaves and chillies.
Concept inspiration: Ideas could include crumbly coconut and rice flour confectionery with tropical fruit flavours and bright pinks, oranges and yellows. In the beverage space, manufacturers might develop boldly coloured RTD bubble teas and juices with tapioca pearls, fruit jellies and tropical fruit flavours.
Gather Together isn’t simply a new colour trend. It’s about using colour, flavour and texture to create experiences that inspire moments of connection.
GNT isn’t simply a plant-based colour supplier either. We partner with our customers to turn behavioural insights into innovative concepts that can truly capture the zeitgeist.
Whether you’re developing confectionery, baked goods, beverages or dairy products, we’ll collaborate with you to find an idea that works for your brand and your market. Together, we can develop innovative food and drink that taps into consumers’ growing desire to gather together.
⮞ To learn more about Gather Together and the four trend directions, visit: https://exberry.com/en/gather-togethercolor-trends

Over the past decade, gluten-free (GF) food development has advanced dramatically. What was once a small niche filled with dense bread, crumbly pastries, and limited beverage options has grown into a dynamic sector shaped by scientific progress and consumer demand. For individuals with coeliac disease - whose only treatment is strict, lifelong avoidance of gluten - these improvements have transformed both the safety and enjoyment of daily eating.



DANA ALEXANDER
Coealiac NZ
Sales and Marketing Manager
Gluten, the protein in wheat, barley, and rye and avenin in oats provides structure, elasticity, and air retention in baked goods. Replacing it is a major technical challenge. Early GF foods relied heavily on refined starches such as rice, tapioca, and potato, which offered bulk but not functionality. The result was often gritty textures, poor rise, and limited flavour, leaving gluten-free consumers with products that were frequently an inferior substitute.
One of the biggest changes in recent years has been the introduction of more varied and nutritionally rich GF flours. Whole-grain gluten-free flours such as sorghum, millet, buckwheat, quinoa, and amaranth now provide fuller flavours, better colour, and improved nutrition compared with the starchheavy formulations of the past.
Pulse flours - including chickpea, lentil, and pea flour - have become particularly important. Their higher protein and fibre content helps mimic some of gluten’s structural qualities, improving dough strength, moisture retention, and overall texture. These ingredients have helped manufacturers overcome some of the most persistent challenges - especially achieving soft, elastic doughs, higher nutritional content and maintaining shelf stability.
Ingredient technology has also played a crucial role in improving gluten-free products. Hydrocolloids such as xanthan gum, guar gum, and hydroxypropyl methylcellulose (HPMC) help create dough resilience and prevent crumbling. Modified starches from corn or tapioca have improved water binding, viscosity, and shelf life. Enzyme technologies further enhance crumb structure and softness. Together, these tools allow manufacturers to replicate key functional properties of gluten and produce items that more closely resemble traditional bakery products.
Innovation in fermentation has improved both flavour and texture in gluten-free baking, as well as alcohol products, such as beer. GF sourdough starters made from flours like buckwheat, sorghum, or rice create doughs with better aeration and moisture retention. Fermentation adds natural acidity and complexity and improves both flavour and texture and can aid digestibility. As artisanal and craft baking trends continue to grow, fermentationbased approaches are becoming increasingly attractive to both small bakeries and large manufacturers.




Another major area of progress is gluten-free beer. Traditionally brewed with barley or wheat, beer was once completely inaccessible to people with coeliac disease. Today, breweries have developed naturally gluten-free beers using grains such as sorghum, millet, rice, buckwheat, and quinoa. These products now offer far more authentic flavour profiles, with improvements in bitterness balance, and aroma bringing them closer to traditional beer styles.
It is important to distinguish these from gluten-removed beers, which are made with barley and later treated with enzymes to break down gluten. The Coeliac New Zealand Medical Advisory Panel advise that these are not reliably safe for people with coeliac disease due to potential residual gluten fragments. For coeliac consumers, naturally gluten-free beers provide the safest and most enjoyable option.
The growing availability of GF beers in restaurants, and supermarkets has had a meaningful social impact. Being able to share a beer with friends or enjoy a drink at a celebration helps reduce feelings of exclusion and allows individuals with coeliac disease to participate fully in social rituals that revolve around food and drink.
Overall, advancements in gluten-free ingredients - from wholegrain flours and functional starches to fermentation techniques and GF beer - have dramatically improved the sensory experience of gluten-free eating.
Importantly, the focus has shifted from simply removing gluten to delivering products that are nutritious, sustainable, and premium quality. Foods are now softer, tastier, and more nutritionally balanced. For people with coeliac disease, these improvements offer more than convenience: they provide normalcy, inclusion, and a better quality of life.
The Crossed Grain Logo remains the gold standard for verified gluten-free assurance in both New Zealand and Australia. Products bearing this certification meet the Food Standards Australia New Zealand (FSANZ) definition of “no detectable gluten” (FSANZ Standard 1.2.7, 2023). Certification is verified through accredited laboratory testing ensuring compliance with the most stringent gluten-free criteria globally.
⮞ For producers, licensing the logo is both a commercial advantage and a compliance safeguard. Operated under annual licence agreements, the programme scales fees to gluten-free turnover and mandates traceability and independent validation of gluten-free status via laboratory product testing. For more information go to coeliac.org.nz


Innova Market Insights has unveiled its Global Flavour Trends for 2026, a comprehensive analysis of the five consumer and market-driven flavour trends poised to reshape the global flavour landscape for 2026 and beyond.




Lu Ann Williams, Innova’s Global SVP of Research, introduced each trend and highlighted standout launches across key food and beverage categories at the annual Global Flavour Trends webinar.
Textures, aromas, and visual appeal are increasingly driving indulgence and perceived value. For instance, 26 percent of Gen Z favour visually striking and surprising flavour combinations. Toppings, seasonings, and sauces remain key avenues for experimentation, with a majority of consumers interested in trying new foods.
Globalisation, travel, and social media continue to fuel the exploration of cross-cultural flavours. Three in five consumers said they were open to trying traditional flavours with a modern twist, and hybrid blends of local and global inspirations are increasingly embraced across categories.
More than 60 percent of Gen Z and Millennials are incorporating protein into their diets. Still, consumers seek a balance between health and indulgence, and taste remains the ultimate deciding factor. Reducing undesired ingredients is also a top priority for consumers around the world.
Occasion-based innovation tied to holidays or milestones turns taste into celebratory moments. Additionally, consumers seek nostalgic and cosy flavours that evoke a sense of tradition and seasonal excitement. Half of consumers also turn to mealtime occasions for flavour experimentation, underscoring meals as personal, expressive experiences.
Consumers increasingly align flavours with mood and emotional needs, embracing taste for self-care, mental well-being, and daily rhythms. In fact, 74 percent of global consumers look to food and beverages to improve their mood when coping with stress. Time of day and emotional state also strongly influence flavour preferences. column

New Zealand’s first AutoStore system has delivered dramatic gains in space, speed and accuracy. For warehouse managers nationwide, the message is clear. Automation drives growth, not cost.




Across New Zealand, warehouse operators face growing pressure from every direction, from rising rents, labour shortages, tighter fulfilment windows and shifting customer expectations. For many, manual operations are no longer keeping pace. What once felt efficient now represents a hidden cost - lost time, wasted space and physical strain on the workforce.
Forward-thinking companies are proving that automation isn’t a cost line, but a value driver. West Auckland based Douglas Pharmaceuticals, one of New Zealand’s leading pharmaceutical manufacturers, has demonstrated how the right technology can deliver lasting operational and strategic returns.
Douglas Pharmaceuticals partnered with Kardex - the fastestgrowing AutoStore™ partner globally, to install New Zealand’s first AutoStore system at its headquarters. Kardex is recognised worldwide for designing and integrating advanced warehouse automation systems that combine efficiency, scalability and innovation.
AutoStore is the world’s most space-efficient Goods-to-Person (GTP) storage system. It consists of a cubic aluminium Grid packed with storage Bins that are retrieved by Robots navigating across its surface, delivering items directly to Workstations. It maximises cubic space and eliminates walking and searching time,
the two greatest inefficiencies in manual warehouses.
For Douglas Pharmaceuticals, the collaboration began with careful planning and modelling. Working closely to manage the change process and ensure minimal disruption. The system was installed alongside existing operations without requiring costly power or infrastructure upgrades.
Since implementation, the transformation has been profound. Douglas Pharmaceuticals achieved a 68 per cent improvement in operational throughput from order receipt to dispatch. The new system occupies only 10 per cent of the footprint previously required by traditional shelving, while increasing storage capacity by 30 per cent, enough to accommodate projected growth for the next five years.
AutoStore now processes over 200 orderlines per hour, compared with just 50 before automation. Accuracy and traceability have also improved dramatically, critical for a pharmaceutical environment where batch sensitivity and expiry dates must be managed precisely. Every product movement is logged automatically, ensuring compliance and peace of mind.
Beyond performance, the shift has elevated the workplace. The AutoStore system eliminates repetitive and strenuous manual tasks, improving staff safety and reducing fatigue. The team has been upskilled and shifted into more rewarding roles, maintaining the full workforce and supported stronger staff morale.
For warehouse managers considering automation, the Douglas Pharmaceuticals project highlights how Kardex AutoStore creates measurable business value:
• Maximising Limited Space
The cubic Grid structure dramatically increases storage density, allowing businesses to expand capacity without expanding their footprint.
• Speed and Accuracy
Goods-to-Person technology delivers faster picking, fewer errors, and near-perfect fulfilment accuracy, driving customer satisfaction.
• Lower Overheads
Energy-efficient Robots and reduced manual labour cut costs while improving throughput and consistency.
• Seamless Scalability
The modular design enables businesses to add Robots, Ports, or Grid capacity quickly, supporting future growth with minimal downtime.
Ryan Gibbs, Warehouse Operations Manager at Douglas Pharmaceuticals, describes the scalability as one of the most powerful benefits: “One of the greatest things about automation is the scalability that it provides.”
Globally, logistics and fulfilment operations are expected to account for more than one-third of capital expenditure by 2030 as companies seek to mitigate risk and build resilience. For New Zealand businesses facing high industrial rents and limited labour capacity, automation is no longer an abstract concept. Its relevance is immediate.
Kardex’s project with Douglas Pharmaceuticals demonstrates how automation can be implemented swiftly, often within months, without disruption to live operations. It delivers a rapid return on investment, typically within two to three years, while building long-term capability that extends beyond efficiency alone.
Automation isn’t about replacing people or chasing futuristic technology. It’s about giving businesses the tools to compete, adapt, and thrive in an increasingly unpredictable market. For Douglas Pharmaceuticals, it has turned a warehouse into a strategic asset, one that delivers speed, safety, and scalability in equal measure.
For New Zealand’s logistics and manufacturing leaders, the lesson is clear: automation isn’t a cost to be justified. It’s value waiting to be unlocked.

After the slump, FoodTech investment is resetting for a rebound. The 2020-2021 boom of capital flooding into FoodTech saw plant-based and cultivated meat startups closing momentous rounds. This flush period was followed suddenly by what felt like a 180° flip in the confidence vote as investment in the industry took a precipitous dive.
This put startups on edge, not only because of reduced funding but because of what appeared to be a change of tone in the market.
However, it seems that this downturn might have been nothing more than a transitory episode giving space for recalibration. The year finished with signs of a revival of interest and capital backing in food innovation by VC’s and CVCs.
The ingredient and food tech company Revyve, B.V. landed €24 million in Series B funding that will accelerate commercial aspirations for its functional yeast proteins designed to replace eggs and additives in mainstream food.
Last year, the leading global specialty minerals company ICL Group, Ltd. announced a follow-on investment in Plantible Foods, Series B funding round for its ROVITARIS® binding solution featuring the abundant aquatic plant Lemna spp., food tech startup Gavan secured $8 million in series A to break into the European food market with its cutting-edge plant protein-based fat solution, Fatrix® and Brevel, Ltd. raised a total of $25 million from leading VCs and strategic investors.
Several food tech players and investors share their take on the future of food tech and investment in this sector.
“After two challenging years, investment activity in food tech and agrifood innovation is showing signs of recovery,” informs Hadar Sutovsky, VP of Corporate Investments for ICL and GM of ICL Planet Startup Hub. Taking CVC to the level, ICL entered the start-up space with the establishment of its FoodTech Startup Accelerator and has, to date, invested in seven companies that, beyond funding, enjoy R&D collaboration and commercialization support.
“While global deal volumes remain lower than the 2021 peak, capital deployment has begun to stabilize and became more selective, with investors concentrating larger amounts in fewer, higher-conviction opportunities,” adds Sutovsky. “The sector appears to be emerging from a period of correction into a more disciplined growth phase driven by technologies that can prove scalability and near-term commercial viability.”
Continued on pg. 22


NutriPR CEO & Founder
Continued from pg. 21
“The downturn was driven by familiar macroeconomic pressures: rising interest rates, limited exits, and investor fatigue in capital-intensive, long-horizon plays,” Sutovsky continues. “Across our own portfolio, Plantible Foods, for example, navigated the cycle successfully by coupling strong technology differentiation with a clear go-to-market strategy and industrial partnerships, closing a significant Series B round in 2024. Arkeon Biotechnologies, GmbH, a highly innovative gasfermentation platform, was unable to secure the same level of follow-on funding despite strong science, illustrating how the constrained fundraising environment has disproportionately impacted early-stage deep-tech ventures.”
Sutovsky notes a paradigm shift in how investors decide where to apply their resources. “Strategic investors are shifting from exploratory bets to partnershipdriven investments, where industrial and technology integration are key. What makes a venture attractive today is less about breakthrough novelty and more about execution readiness, validated
unit economics, a clear regulatory path, tangible customer pull, and scalability. The next wave of investment is likely to favor ventures that bridge sustainability with performance, science with manufacturability, and innovation with real market traction.”
“Food tech matured quickly,” asserts Itay Dana, co-founder and Chief Business Development Officer for Novella Innovative Technology Ltd., a plant-cell technology company that developed a platform to deliver consistent, high-value bioactives for nutraceuticals and functional foods.
“The noise of 2020–2021 has settled, and what’s left is a market that values real depth with long-term logic, broad demand, and business models that can scale without heavy infrastructure. The focus has shifted from disruption to integration.”
“Consumers haven’t changed as much as some believe,” says Dana. “They still look for what has always mattered: products that are affordable, healthy, enjoyable to eat, and ideally carry some sustainability value. Global instability is reshaping priorities.

Supply chains have proven fragile, affected by wars, climate, and logistics costs, and that’s pushing the industry toward shorter, more local production cycles. There’s a growing demand for technologies that can bring manufacturing closer to the point of consumption and reduce dependency on global sourcing.”
Dana cites an example of this pattern. “A clear representation of this shift is the growing focus on fermentation technologies. They represent a practical, scalable way to meet industry’s new priorities: producing essential food components locally and efficiently.”
Regarding traction in investment, Dana adds: “Food tech isn’t cooling down; it’s focusing. The next wave belongs to ventures that combine solid science, market logic, and consumer understanding, companies that know innovation only works when it fits naturally into the way people eat and live.”
Brevel is the first climate-centered foodtech company to globally commercialize illuminated-fermentation technology, producing high-value, light-dependent
ingredients at scale. Yonatan Golan, Cofounder and CEO of Brevel looks ahead to an industry that is becoming more patient and grounded.
“Let’s face it, many VC-backed startups are not ‘VC-backable,’ expresses Golan. “An investment bubble further accelerates this situation, especially in a new category as volatile as food, a sector which only began gaining VC attention around 2015. VCs, family offices, CVC, and even some PE firms jumped to invest in everything and anything, plant-based brands, novel ingredients, cultivated meat, and precision fermentation. Many of these concerns were not mature enough to deliver the returns. In this situation it is impossible to separate signal from noise, and the whole ecosystem becomes oversaturated with capital. This left the food tech ecosystem badly hit and in urgent need of more capital than was practically available.”
“It seems that finally the ripples from the burst bubble have calmed down, and the ecosystem as a whole is starting to pick up,” Dana observes. “Investors will see who survived the storm, recalibrate expectations to be more realistic. Today’s investors are leaning more toward upstream
processes and ingredients, with strong and differentiating IP with a real added value for the industry. They are seeking more mature, minimal-risk companies that actually deliver on their promises and maintain a clear path to profitability. I believe that we will get to a point where we dramatically change the way food and ingredients are produced, but real change takes time no matter how much money you throw at it.”
While still not at the levels it was in its heyday, investments in food tech are climbing up again after a difficult period. Last fall, the Good Food Institute, in its analysis of data compiled by the research firm Net Zero Insights, reported a jump in venture capital investments in the alternative protein space of nearly a quarter-billion dollars in the year’s third quarter, as compared to around half that in Q2 of that year. According to that report, the majority of the focus was on plant-based proteins with more than $142 million invested. Just above 100 million went toward precision fermentation sources. Europe led the way, with the US still playing catch-up.

These predictions highlight flavours expected to trend in retail, food service, and beyond throughout the coming year.

“To continue delivering product development solutions that meet consumers’ unique and changing needs, we stay attuned to industry and market trends, keeping a pulse on what’s relevant now and in the future,” said Nicole Potash, Tastepoint general manager.
“Our annual flavour trend predictions reflect a vibrant mix of influences, from nostalgia-driven classics to global favourites gaining momentum in the US, as well as bold new combinations. We hope this year’s list provides brands with valuable insights and fresh inspiration to create products that excite the senses and spark imagination.”
At the intersection of science and creativity, Tastepoint draws on decades of experience to guide brands in developing trend-driven food and beverage products that ignite inspiration and delight consumer palates.
Each year, Tastepoint forecasts ten flavour trends based on data-driven market analysis, foodservice menu tracking, social listening, and changes in consumer behaviour.
The 2026 list offers insights across categories, including confectionery, beverages, dairy, culinary, snacks and bakery. It reflects key trends such as nostalgia and better-for-you, and identifies global flavours expected to gain traction in North America.
THE TOP 10 FLAVOURS TO WATCH IN 2026 ARE:
• Mandarin: Already popular in juices and sparkling beverages, this citrus favourite is poised to expand into cocktails, coffee, frozen novelties, salad dressings and sauces.
• Cherry: The sweet and tart flavour of cherry delivers a powerful sense of nostalgia and is expected to lead new beverage launches and to appear in snack bars, mixes, confectionery, and dairy applications.
• Sweet Corn: Historically a staple dish worldwide, sweet corn is seeing renewed interest. Driven by the popularity of Mexican street corn, or Elote, and other global favourites, its versatility continues to expand.
• French Onion Soup: A timeless comfort food, its deep, savoury profile is projected to move into new menu applications.
• Cola: With its iconic flavour profile currently experiencing a resurgence, cola is expected to move beyond beverages and into unexpected categories such as ice cream and bakery.
• Limoncello: As consumers seek authentic, premium experiences, this quintessential Italian liqueur is expected to influence new categories, from baked goods to ready-to-drink teas and coffees.
• Sweet Heat: Often known as “swicy”, the crave-worthy combination of sweet and spicy flavours is gaining traction, expanding beyond culinary and snack items into ice cream, cocktails, and beyond.
• Pancake: This comforting, sweet flavour is expected to move beyond breakfast and appear in a wide range of new formats, suitable for scoop shops or late-night snacks.
• Tiramisu: Offering a decadent, layered flavour experience, tiramisu-inspired products are well-positioned to appear in categories beyond the bakery space.
• Chai Spice: With chai’s rise as a global favourite, its sweet-and-spicy profile is gaining popularity in food and beverage applications. Its aromatic depth offers a comforting yet elevated alternative to traditional warming spices.
Tastepoint by IFF is a leading innovator of taste, driven by a commitment to providing customers and their consumers with exciting and memorable flavour and ingredient experiences.
The perfect blend of heart and science, Tastepoint integrates state-of-the-art technology, world-class production facilities and passionate food scientists to deliver products that ignite the palate and the imagination.

Snacking has firmly moved beyond the space between meals in 2026, functioning as breakfast replacements, afternoon energy boosts, post-workout fuel, and late-night indulgences.

For food and beverage manufacturers, this shift has signalled a clear opportunity and a higher bar. Snacks must now deliver on nutrition, craveability, convenience, and value, often within a single product. As consumer expectations continue to evolve, the snack category is being reshaped by a blend of functional benefits, sensory-driven indulgence, and practical formats designed for everyday routines.
Better-for-you snacks are no longer niche; they are expected. However, the focus has moved away from strict reduction claims and toward proactive benefits. Protein, fibre, and digestive support have become standard features across both sweet and savoury snacks, driven by consumers looking for sustained energy and fullness throughout the day.
This shift has influenced formulations across bars, baked snacks, extruded formats, and refrigerated options. Products that successfully combine functional nutrition with indulgent taste have gained traction, particularly those that can be positioned as everyday solutions rather than specialty health items. Clear, simple benefit messaging has continued to resonate, especially when paired with familiar formats that reduce trial hesitation.
In 2026, texture is doing more of the heavy lifting. Multitextural snacks, those that combine crunch, creaminess, airiness, or chew, have been increasingly associated with premium quality and indulgence. Even traditional flavour profiles have been refreshed through structural innovation rather than new flavour introductions alone.
Global flavour exploration remains a key driver of snack innovation, but consumer expectations have shifted toward more precise regional cues. Broad “international” descriptors are giving way to flavours inspired by specific cuisines, ingredients, and seasoning traditions.
This emphasis on mouthfeel allows brands to elevate classic snack categories while maintaining familiarity. It also supports portion-controlled formats, where fewer bites can still deliver a satisfying experience. Texture-forward design has become a key differentiator, particularly in crowded segments like bars, chocolate snacks, and salty snacks.
Sweet-heat flavour combinations continue to gain momentum, moving decisively into the mainstream. Once considered adventurous, sweet and spicy profiles are now appearing across a wide range of snack applications, from seasoned nuts and popcorn to bars and bite-sized confections.
Rather than extreme heat, the most successful profiles balance gentle spice with sweetness and acidity, creating layered flavours that feel bold but accessible. Fruit-forward sweetness paired with chilli, pepper, or warming spice remains especially effective, offering excitement without overwhelming the palate.
Global flavour exploration remains a key driver of snack innovation, but consumer expectations have shifted toward more precise regional cues. Broad “international” descriptors are giving way to flavours inspired by specific cuisines, ingredients, and seasoning traditions.
Snacks provide a low-risk entry point for these flavours, allowing consumers to explore global tastes in familiar formats. Seasoned chips, crackers, puffs, and coated nuts continue to serve as ideal vehicles, offering high flavour impact with minimal commitment. Simplicity remains important as one strong global influence often resonates more than overly complex fusion concepts.
Portion consciousness has continued to shape snacking behaviour, influenced by wellness goals and changing attitudes toward eating. Rather than eliminating indulgence, consumers have been gravitating toward smaller, intentional moments of enjoyment.
This has driven growth in bite-sized snacks, mini bars, thins, and portioned treats that balance indulgent flavour with nutritional credibility. Products positioned as mindful rewards or planned snack breaks tend to resonate more strongly than those framed around restriction or guilt.
Economic pressure and private label growth continue to influence purchasing decisions, making value a critical consideration in snack innovation. In 2026, value is defined less by low price and more by perceived worth, quality ingredients, functional benefits, and satisfying sensory experiences.
Successful snack portfolios often feature clear tiering, allowing brands to meet different price points without diluting brand equity. Strategic portioning, thoughtful ingredient selection, and format innovation are playing an increasingly important role in maintaining margins while delivering products that still feel premium and intentional.
Everyday ingredients have also been reintroduced as heroes. Nuts, seeds, grains, and simple bases have been gaining renewed attention when paired with elevated processing techniques, seasoning strategies, or sourcing cues.
This ingredient-led approach aligns naturally with both functional nutrition and premium positioning. Roasting styles, seasoning craftsmanship, and texture refinement allow even minimal-ingredient snacks to stand out. Pistachios, almonds, seeds, and grain-based snacks continue to offer versatility across sweet and savoury applications.
As snacking happens across more occasions and environments, packaging has become a critical component of product success. Resealability, portability, and portion control are now baseline expectations rather than value-added features.
Multipacks and variety packs are increasingly used to encourage trial, especially for new flavours or functional formats. In foodservice and convenience settings, display-ready and grab-andgo packaging continues to support impulse purchases and crossmerchandising opportunities.
The most successful snack innovations in 2026 will not rely on a single trend. Instead, they will integrate multiple consumer needs, combining function with indulgence, bold flavour with approachability, and value with experience.
As snacking continues to replace traditional meals and expand into new dayparts, the opportunity lies in building products that feel intuitive to consume, satisfying to repeat, and adaptable to evolving routines. In an increasingly competitive category, snacks that strike this balance will be best positioned for long-term growth.

A booklet produced in 2025 by the Rotoiti 15 trust, Department of Conservation and Scion – now part of the Bioeconomy Science Institute – aims to help people identify insect pests and diseases.
The booklet, ‘Common insect pests and diseases of New Zealand native plants’, helps protect indigenous plant health. It can be used to help educate people about plant diseases, allowing them to broadly identify what insect pests and diseases they may come across.
New Zealand’s native species have a range of insect pests and diseases associated with them. Many of these are native, common and not known to cause significant damage. The booklet can help readers separate these common diseases from potentially new diseases – such as myrtle rust or kauri dieback – that could damage native trees. Each insect pest and pathogen is described in detail, with large photographs to make identification easy. A glossary with the Māori and scientific names of insect pests, diseases and host plants is included.
The booklet was a result of Te Rātā Whakamaru, a collaborative programme between Scion, Rotoiti 15 trust and the Department of Conservation funded by Jobs for Nature. The programme’s role was to create jobs that supported nature. Te Rātā Whakamaru established roles for surveying and monitoring myrtle rust in the Bay of Plenty and sought to identify possible disease-resistant ramarama and rōhutu plants for the propagation of resistant planting material.
⮞ Any suspected new diseases or pests should be reported to the Ministry of Primary Industries on 0800 80 99 66 or at https://report.mpi.govt.nz/pest.
As a leading recycling, paper and cardboard packaging business, Opal has a clear view of the emerging trends shaping the packaging industry.
As packaging continues to evolve, sustainability, efficiency and customer experience are at the forefront of packaging trends. Businesses are seeking recyclable materials, durable packaging designs and engaging unboxing experiences. At Opal, we are delivering the packaging solutions our customers need to create value into the future.
Company sustainability goals and an increase in consumer interest are driving the demand for more recycled content in packaging. Opal’s partnership with John Dee, a leading meat processor, demonstrates how recycled paper and recyclability can be integrated into high-performance packaging.
• John Dee’s chilled meat boxes now contain 73 per cent recycled content, up from 48 per cent.
• The bases of frozen meat boxes have increased from 35 per cent to 66 per cent.
• The lids of frozen meat boxes have risen from 37 per cent to 69 per cent.
By leveraging Opal’s Dura-Flute Mediums and Premium Recycled Liner, Opal developed a solution that maintains strength and durability, even in high-humidity conditions. This ensures John Dee meets its sustainability goals without compromising on performance.
Packaging is no longer just about protection – it offers the opportunity to bring a brand’s personality to life and create an impactful unboxing experience for consumers. Brands are looking to create packaging that is functional, visually engaging and features unique design elements including:

• Thoughtful structural design that ensures packaging is easy to open while protecting the product inside.
• High-quality printing and die-cutting that showcases colour and adds tactile depth to packaging, delivering a premium feel.
• Using materials that are recycled and recyclable, with certifications that demonstrate cardboard products are manufactured with responsibly sourced wood fibre.
Consumers are driving changes in the packaging industry by moving away from plastics. Fresh food producers and FMCG brands that rely on cold storage are now expected to provide packaging that includes recycled materials that can be recycled when it can no longer be used.
This presents a challenge for fresh food producers who rely on the thermal capabilities of Expanded Polystyrene (EPS) to keep their produce fresher for longer. For example, EPS is a common solution, but it is difficult to recycle within kerbside recycling systems.
Opal solved this problem for Petuna Seafoods by developing a corrugated cardboard alternative to its whole fish packaging solution. The design features moisture barrier properties that withstand low temperatures for fresh chilled products, and a functional coating allowing imagery to be laid down onto kraft paper.
From increasing the use of recycled materials to optimising packaging for eCommerce, Opal’s commitment to sustainability, performance and design ensures businesses can continue to meet evolving consumer demands.





Put to work our technical ingenuity and industryleading portfolio to create futureforward nutrition solutions with flavours, colours, specialty ingredients and more. We bring more than a century of global expertise to Australia & New Zealand. Your Edge. Our Expertise. Let’s create. adm.com/ADM-Nutrition-ANZ






Vacpack is a leading provider of innovative machinery and cardboard base food packaging products to New Zealand, Australia and the Pacific.
Are you looking for eco-friendly packaging that improves the shelf life of your fresh and frozen items? Then, Vacpack’s market leading cardboard base technology is the solution for
you. The systems help reduce plastic by up to 80%, is 100% biodegradable or recyclable and creates an appealing and safe end-product. Call us now to find out more.








Protect your brand solutions that enhance food safety and weight compliance for processing lines.





info@easirecycling.co.nz
www.easirecycling.co.nz
Freephone: 0800 342 3177


www.gribblesscientific.co.nz


EXBERRY® Colours are the ideal and future-proof solution for food and drink applications matching the recent plant-based, vegan and vegetarian trends.

After many years of successfully selling the SHINI & Yu Ting range of air and water cooled chillers, MACHINETECH AND COOLTEK have partnered with Teyu (S&A) Chillers to supply a more extensive range of products for the food, pharmaceutical, and engineering industries.

Water Chillers now in stock for immediate delivery and inspection.
Please contact Brendon or Phillip to select the chiller as per your requirements, no matter the size, single or 3 phase. For more information, email on cooltek@machinetech.co.nz or info@machinetech.co.nz Ph: 09 633 0071 | www.cooltek.co.nz




HRS Heat Exchangers operates at the
Pasteurisation
Sterilisation
Aseptic Filling
Direct Steam Injection
Evaporation
CIP Kitchens
Process Skids
Juice Crushing and Remelting



NZMS Scientific offers specialised solutions to help ensure your products meet the standards you and your customers expect.
Give us a call today to talk about:
• Pathogen testing
• Allergen testing
• Hygiene testing
• Sterility testing

SCANZ is a multi-discipline supply company and manufacturers agent, specialising in technology and equipment for the food industry. It’s primary focus is within three market segments, namely fish (including aquaculture), meat and the dairy industry. Recent advances have been made in Impingement and IQF Freezing technologies from OCTOFROST of Sweden, plus an expanded processing role in Petfood.
SCANZ provides solutions to suit all phases of the production process.

Talk to us today, info@scanztech.com or 09-520 2544. www.scanztech.com





Antimicrobials
Bespoke blends
Caramel colours & burnt sugars
Cocoa powder


Dehydrated
Flavours:
Hydrocolloids
Modified
Phosphates & fortification
Proteins: plant & animal
Sweeteners & starch derivatives



Urgent Couriers are specialists in temperature -controlled deliveries of chilled small goods. Fast, reliable, guaranteed sameday services live tracked from despatch all the way to your customer’s door. We provide techforward and innovative solutions to make your life easier.


+64 9 307 3555 P sales@urgent.co.nz E





















































With over 40 years operating experience in New Zealand, TC Transcontinental Packaging New Zealand (TC NZ) is a leading manufacturer of flexible packaging to the FMCG, horticulture, retail and manufacturing markets
TC NZ is both a reputable manufacturer and trader, supplying all forms of flexible packaging made from traditional plastic films recycled blended films, laminated barrier substrates. TC NZ employs over 90 people in New Zealand with centres in Auckland and Christchurch, home to an ultra-modern food grade packaging manufacturing plant, and supported by our global TC Transcontinental research and technology platform from North America.
TC Transcontinental Packaging brings a distinctive blend of science, technology, and art together to create flexible packaging that preserves our customers’ products and accentuates their brands on the store shelf. Our expertise, resources and conversion technology helps us create packaging that gives our customers a competitive advantage. We utilise a widevariety of printing techniques, laminations and converting styles including pouches that help enhance your brand.
We invest in state of the art technology to offer and invest in a sustainable future and are delighted to be recognised for our high quality packaging that we supply to our customers. Globally TC Transcontinental Packaging is committed to a circular approach to plastic. As global signatories to the Ellen MacArthur Foundation, we are working towards our 2025 goal where 100% of our plastic packaging will be reusable, recyclable or compostable, and 10% of our plastic output to be made from recycled plastic waste.


At the 2022 Pride in Print Awards, TC NZ were awarded Gold Sustainability Award in the Flexible Packaging Category for our significant volumes used into industrial, refuse and hygiene packaging. TC NZ are meeting customer requirements by extruding and converting recycled resins of in-house, postindustrial waste, and post-consumer recycled content , Green PE (PE derived from renewable resources such as waste sugar cane), and has the ability to manufacture flexible packaging with other



ABB has two manufacturing facilities in New Zealand located in Henderson, Auckland and Napier.
Email: contact.center@nz.abb.com
T: 0800464222
https://campaign.abb.com/Food_and_ Beverage
Contact us for:
• Equipment Regulatory
• Process Control Services
• Events & Education Services

10A Julius Avenue, Suite 1, Ground Floor, Sydney, 13682, 2113, Australia
Contact: Zona Negri
T: +61 2 8879 4800
E: nutritionanz@adm.com
Contact us for:
• Alternative Proteins
• Bakery & Cereals
• Beverage, Clean Label
• Confectionary
• Dairy
• Emulsifiers & Stabilisers
• Flavours & Colours
• Functional
• IngredientsPrebiotic fibre
• Pro & Post-biotics
• Natural extracts
• Sweeteners

Level 2, Building C, 602 Gt South Road
Ellerslie, Auckland, New Zealand
T: +61 03 9559 8306
E: lisa.gilbert@brenntag-asia.com
www.brenntag.com/food-nutrition
Contact us for:
• Bakery & Cereals
• Beverages
• Clean Label
• Confectionery
• Cultures
• Enzymes & Yeasts
• Dairy
• Emulsifiers & Stablisers
• Fats & Oils
• Flavours & Colours
• Functional
• Ingredients
• Ingredients
• Nutrition
• Organic & Free From
9A Apollo Drive, Rosedale
Auckland, New Zealand
T: +64 0800 442 783
E: orders@brookefinefoods.com www.brookehl.co.nz
Contact us for:
• Ingredients

43 Maurice Road, Penrose, Auckland, 1061, New Zealand
Contact: Richard Hanna
T: +64 9 622 4601
E: info@awsgroup.co.nz www.awsgroup.co.nz
Contact us for:
• Equipment
• Comprehensive cleaning and sanitising solutions
Brands
• Envirolyte Generators
• Bioglo Spectrascopes
49 Barry Street, Bayswater
Victoria, Australia
Contact: Scott Bolch
T: 61 439 355 575
E: aucustomerservice@chr-hansen.com www.chr-hansen.com
Contact us for:
• Alternative Proteins
• Beverages
• Clean Label
• Cultures, Enzymes & Yeasts
• Dairy
• Food Safety
• Ingredients
• Ingredients
• Sustainability & Food Waste
• Testing & Analysis

46 Onslow Street, Rockdale, Invercargill, 9812, New Zealand
Contact: Brad Reynolds
T: +64 27 567 7568
E: brad@conceptsolutions.co.nz
www.conceptsolutions.co.nz
Contact us for:
• Equipment

20 Peters Way, Silverdale
Auckland, New Zealand
T: +64 9 421 9019
E: lane@caspak.co.nz www.caspak.co.nz
Contact us for:
• Labelling
• Materials & Packaging
3 Piermark Drive, Albany, Auckland, New Zealand
Contact: James Romhany
T: +64 9 415 4580
E: info@confoil.co.nz www.confoil.co.nz
Contact us for:
• Labelling
• Materials & Packaging

112A Mays Road, Penrose
Auckland, 1061, New Zealand
Contact: Phillip Cashmore
T: +64 9 633 0071
E: cooltek@machinetech.co.nz
Contact us for:
• Equipment
• Cooling Towers
• Water Chillers


4/3 Emirali Road, Silverdale
Auckland, New Zealand
Contact: Tim Morton
T: +64 9 443 6301
E: info@vacpack.co.nz www.vacpack.co.nz or www.dlpack.co.nz
Contact us for:
• Labelling
• Materials & Packaging
• Equipment
• Food Safety
• Cook Chill
• Sustainability & Food Waste
Brands:
• Benison
• Airzero
• EkoPak
• Frimaq
• Regethermic
• Turbovac
• Vacpack

5 Reliable Way, Mt Wellington, Auckland, New Zealand
Contact: Customer Service
T: 0800 335 624
E: enquiries@delmaine.com www.delmaine.co.nz
Contact us for:
• Beverage, Toppings & Sauces
• Chilled
• Antipasto
Brands:
• Delmaine
• Rosedale
• Pelion
• Longest Drink in Town
• Tuimato

14 Totara Heights Way, Paihia, 0200, New Zealand
Contact: Jon Earnshaw
T: +64 21 053 1730
E: jon@easirecycling.co.nz
Contact us for:
• Sustainability & Food Waste
• Waste Management


750C Great South Road, Penrose Auckland, New Zealand
Contact: Tom Aldridge T: +64 9 579 1990
E: taldridge@eurotec.co.nz
www.eurotec.co.nz
Contact us for:
• Equipment
• Food Safety

150 Main Street, Pahiatua, 4910, New Zealand
T: +64 6 376 8774
E. info@foodflo.co.nz
W: foodflo.co.nz
Contact us for:
• Ingredients
• Inclusions

17A Cook Street
Cambridge, New Zealand
T: +64 7 823 4111
E: sales-nz@fortresstechnology.com
https://fortresstechnology.co.nz/
Contact us for:
• Equipment

5/2 Kellow Place, Wiri, Auckland, New Zealand
Contact: Gavin Carragher T: +64 9 262 0995
E: support@galas.co.nz
E: support@galas.com.au www.galas.co.nz
Contact us for:
• Audits & Certification
• Bakery & Cereals
• Beverage
• Chilled
• Clean Label
• Confectionery
• Dairy
• Equipment
• Food Safety
• Fresh
• Functional
• Inspection & Sanitation
• Labelling
• Materials & Packaging
• Logistics
• Process Control
• Services
Brands:
• Best Code
• Bluhm Systems
• Ijet
• Marroprint
• Print Date
• Printjet
• RN Mark

Industrieweg, 26, n/a, Mierlo, 5731HR, Netherlands
Contact: Lorraine Jansen
T: 0407800300
E: info@gnt-group.com
Contact us for:
• Flavours & Colours

Invermay Research Centre (Block A), Puddle Alley, Mosgiel, Dunedin, 9053, New Zealand
Contact: Brent Hananeia
T: 03 489 4600
E: sales@gribblescientific.co.nz
Contact us for:
• Product testing / analysis

160 State Highway 2, RD11, Masterton, 5871, New Zealand
Contact: Alistair Rough
T: 06 370 0200
E: alistairr@hmstn.co.nz
Contact us for:
• Contract Manufacturer

43 Maurice Road, Penrose, Auckland, 1061, New Zealand
Contact: Stuart Jones
T: +64 9 622 2720
E: sales@hawkinswatts.com
Contact us for:
• Alternative Protein
• Bakery & Cereals
• Beverage
• Clean Label
• Confectionery
• Dairy
• Emulsifiers & Stabilisers
• Flavours & Colours
• Functional
• Ingredients
• Sugars & Starches

C/- Kaikaha Building, 70A Business Parade South Highbrook, Auckland 2013, New Zealand
Contact: Gavin Fantastic
T: +64 218 79301
E: gavinfantastic@hibiscus-solutions.com
Contact us for:
• Alternative Protein
• Bakery & Cereals
• Beverage
• Clean Label
• Confectionery
• Cultures
• Enzymes & Yeasts
• Dairy
• Emulsifiers & Stabilisers
• Equipment
• Fats & Oils
• Flavours & Colours
• Functional
• Ingredients
• Labelling
• Materials & Packaging
• Sugars & Starches
• Supply Chain & Logistics
• Sustainability

351 Rosebank Rd, Avondale, Auckland, 1026, New Zealand
Contact: John Miller
T: +64 9 828 4180
E: sales@honar.co.nz
Contact us for:
• Equipment

8/168 Christmas Street, Fairfield Melbourne, Australia
E: info@au-hrs-he.com
www.hrs-heatexchangers.com.au
Contact us for:
• Equipment
• Processing Technology

278 Kahikatea Drive, Frankton, Hamilton, 3204, New Zealand
Contact: Jared Knapp
T: +64 7 847 5333
E: sales@industrialtube.co.nz
Contact us for:
• Food Grade Stailess Steel Tubing
• For food processing and hygienic application
19 Beasley Ave, Penrose, Auckland, 1061, New Zealand
Contact: Derek Beckett
T: +64 27 532 4474
E: derek@instrumatics.co.nz
Contact us for:
• Equipment
WANT TO BE IN FRONT OF THE INDUSTRY? Don’t miss out on the 2027 Buyer’s Guide. BOOK NOW!
email: info@reviewmags.com

117 Cryers Road, East Tamaki, Auckland 2013, New Zealand
Contact: Alexis Thorley
T: +61 408 946 264
E: alexis.thorley@invitaanz.com www.invitaanz.com
Contact us for:
• Alternative Protein
• Bakery & Cereals
• Beverage
• Clean Label
• Confectionery
• Cultures
• Enzymes & Yeasts
• Dairy
• Emulsifiers & Stabilisers
• Fats & Oils
• Flavours & Colours
• Functional
• Ingredients
• Sugars & Starches
Brands:
• dsm-firmenich
• BENEO
• Cargill
• AAK
• Advanced Lipids
• GNT
• Futura
• QHT
• IFF Health
• Ransom Naturals
• Benexia
• OVĀVO
• Totally Natural Solutions
• Coffein Compaigne
• F&C Licorice
• Nigay
• O’Laughlin
• Stabil Nutrition
• PureMalt
• abvickers
• Smart Salt®
• Veramaris® Pets

151 Hutt Park Rd, Gracefield, Lower Hutt, 5010, New Zealand
Contact: Thomas Kaffes
T: 0800 425 223
E: info@label.co.nz
Contact us for:
• Labelling
• Materials & Packaging

L2, Building 6/660 Great South Road Ellerslie, Auckland 1051, New Zealand
Contact: Kenny Pihema
T: +64 9 965 5185
E: kpihema@hjlangdon.com www.hjlangdon.com
Contact us for:
• Alternative Protein
• Clean Label
• Emulsifiers & Stabilisers
• Flavours & Colours
• Functional
• Ingredients
• Sugars & Starches

202 Parnell Road
Parnell, Auckland
Contact: Jon McGrinder
T: +64 09 309 0802
E: sales@jamescrisp.co.nz
www.jamescrisp.co.nz
Contact us for:
• Ingredients

Contact: Rod Enoka 3/62 Hillside Road Glenfield, Auckland
Phone: +64 9 446 0709
Email: rod@miltek.co.nz
Website: www.miltek.co.nz

16 Hannigan Drive, Saint Johns, St Johns, Auckland, 1072, New Zealand
Contact: Ali Spencer
T: +64 21 743 209
E: ali.spencer@pacfic-flavours.co.nz pacific-flavours.co.nz
Contact us for:
• Alternative Protein
• Bakery & Cereals
• Beverage
• Cbd & Hemp
• Clean Label
• Confectionery
• Cultures, Enzymes & Yeasts
• Dairy
• Emulsifiers & Stabilisers
• Flavours & Colours
• Fresh
• Functional
• Ingredients
• Sustainability
Brands:
• Pacific Flavours & Ingredients
• Metier
330 Lagoon Creek Road RD2, Te Anau, New Zealand
Contact: Jo Daley
T: +64 27 856 2867
E: info@kiwisaffron.com www.kiwisaffron.com
Contact us for:
• Ingredients

we’ve got great products for every occasion, from fresh seafood to crumbed fish and tasty tapas.

Level 3, 5 Short Street, Newmarket, Auckland, 1023, New Zealand
Contact: Alex Stone
T: +64 22 503 6557
E: alex.stone@pacifictradeinvest.com
Contact us for:
• We support expopters of fine food products from the Blue Pacific to New Zealand

1 Workspace Drive, Hobsonville, Auckland, 0618, New Zealand
Contact: Sharon Burkett
T: +64 9 444 1676
E: sales@sherratt.co.nz
Website: www.sherratt.co.nz
Contact us for:
• Alternative Proteins
• Bakery & Cereals
• Beverages
• Brines & Cures
• Clean Label
• Dairy
• Emulsifiers & Stabilisers
• Flavoured Seasoning blends
• Flavours & Colours
• Functional and Bespoke Blends
• Hydrocolloids
• Ingredients
• Proteins
• Sugars, Sweeteners & Starches
1/164 Remuera Rd, Auckland, 1050, New Zealand
Contact: Tony Rumbold
T: +64 21 992 750
E: info@scanztech.com
Contact us for:
• Equipment

5 Doraval Place, Mt Wellington, Auckland, 1060, New Zealand
Contact: Nicolas Sawyer
T: +64 9 270 8510
E: salesnz@sensient.com
Contact us for:
• Flavours & Colours
• Organic & Free From
• Sustainability & Food WasteSpecialty Sauces

Address: 42B Tawa Drive, Albany, Auckland
Contact Name: Donald Lee
Phone: 021 481 245
Email: donald.lee@tc.tc www.tctranscontinental.com

1 Portage Road, New Lynn, Auckland, New Zealand
T: 0800 603 603
E: info@tsclabelprinters.co.nz www.tsclabelprinters.co.nz
Contact us for:
• Labelling
• Materials & Packaging

239D Burswood Drive, Burswood, Auckland, 2013, New Zealand
Contact: Bronwyn Addington
T: +64 9 274 9825
E: info@temprecord.com
Contact us for:
• Equipment

1/46 Aylesbury Drive, Altona, Victoria, 3018, Australia
Contact: Colin Seddon
T: +61 1300 703 161
E: colin.seddon@wipotec.com www.wipotec.com/au
Contact us for:
• Equipment, Supply chain & Logistics
Brands:
• Wipotec

626 Rosebank Road, Avondale, Auckland, 1026, New Zealand
Contact: Carla Dagger
T: +61 41 229 9823
E: info@zymus.net www.zymus.net
Contact us for:
• Alternative Protein
• Bakery & Cereals
• Beverage
• Clean Label
• Confectionery
• Cultures, Enzymes & Yeasts
• Dairy
• Emulsifiers & Stabilisers
• Flavours & Colours
• Functional, Ingredients

























































































